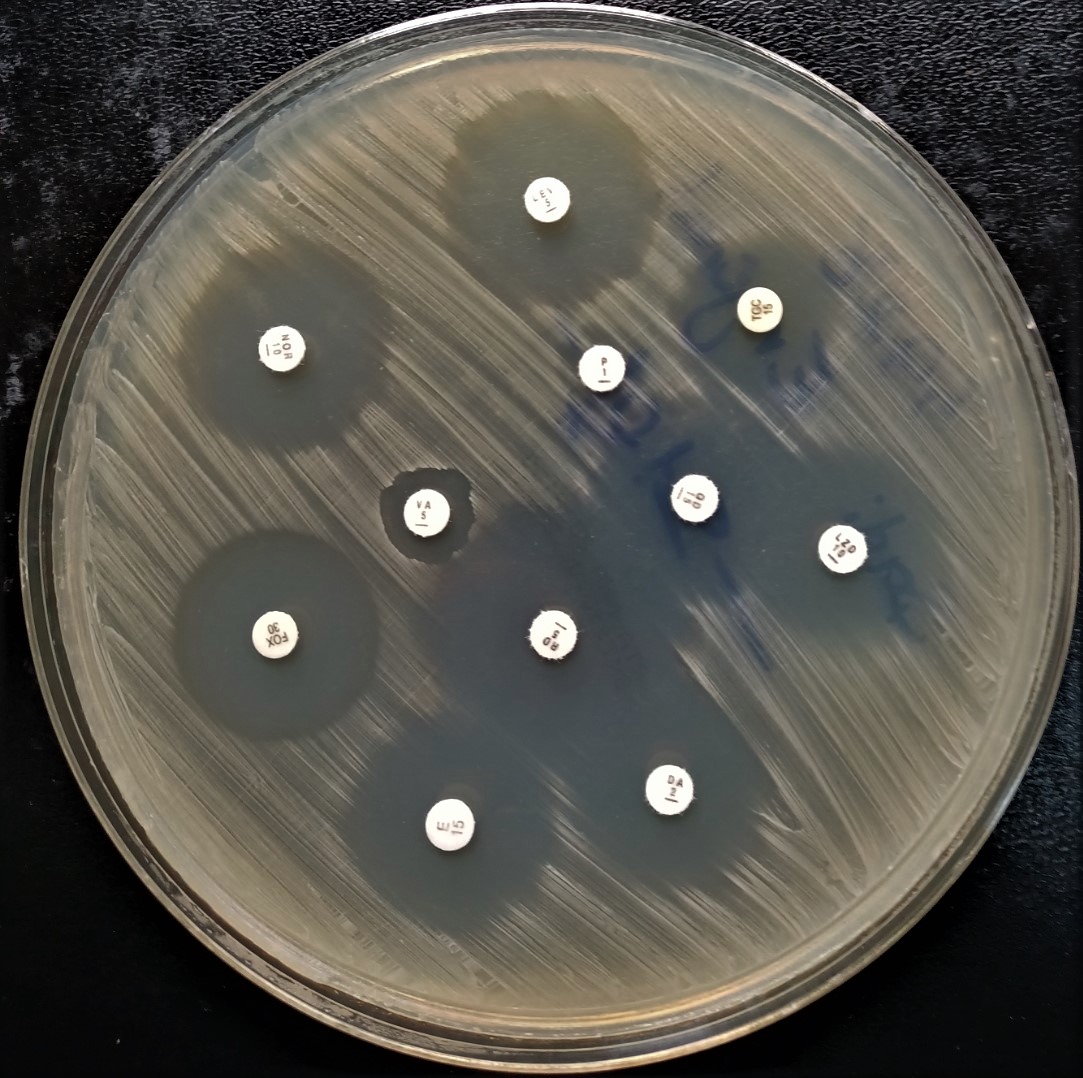
Antibiogram Roboflow Universe

Interpreting The Antibiogram

Antibiogram Reading Antibiogram Reading An interpretative reading of an antibiogram aims to analyze the overall susceptibility pattern, not just the result for an individual antibiotic, and so to predict the underlying resistance. Many major guidelines recommend using antibiograms to inform treatment selection and improve antibiotic use. however, individual clinicians may not be familiar with antibiograms and their importance in antibiotic prescribing and antimicrobial stewardship.

Antibiogram Reading Easy And Accurate The main concept is the “clinical categorization" there is a well developed system of interpreting the results of all these methods and it is called as breakpoints of antibiotics. breakpoints help to categorize the pathogen into the either of the 3 categories, susceptible, intermediate or resistant. An antibiogram displays the overall susceptibility of bacteria to a variety of antibiotics. antibiograms can be used to guide empiric antibiotic therapy and to identify and monitor resistance trends to antibiotics. An antibiogram (or cumulative antibiogram) is a graphical report (usually a table) that lists the percentage of isolates of various bacteria that are susceptible to various antibiotics over a defined period of time. Learn to read and interpret antibiograms to make informed antibiotic decisions and combat antimicrobial resistance.
Antibiogram Roboflow Universe An antibiogram (or cumulative antibiogram) is a graphical report (usually a table) that lists the percentage of isolates of various bacteria that are susceptible to various antibiotics over a defined period of time. Learn to read and interpret antibiograms to make informed antibiotic decisions and combat antimicrobial resistance. Learn what s, i, r, and mic values mean on an antibiogram and how to use resistance patterns to make smarter antibiotic choices. Setting up an analysis: %ris and test measurements in the main analysis screen, there are three sections on the left that you must answer: analysis type, organisms, and data files. on the right, there are some additional options that may be useful to you. Learn practical examples and tools to leverage antibiogram data and information across your organization analyze and present a cumulative antibiogram at least annually generate local facility specific data include only final, verified test results. The document covers various topics related to antibiograms including how they are tested, interpreted, and documented. it emphasizes the importance of generating antibiograms using standardized methods and interpreting them carefully based on multiple factors. download as a pptx, pdf or view online for free.

Antibiogram Vector Learn what s, i, r, and mic values mean on an antibiogram and how to use resistance patterns to make smarter antibiotic choices. Setting up an analysis: %ris and test measurements in the main analysis screen, there are three sections on the left that you must answer: analysis type, organisms, and data files. on the right, there are some additional options that may be useful to you. Learn practical examples and tools to leverage antibiogram data and information across your organization analyze and present a cumulative antibiogram at least annually generate local facility specific data include only final, verified test results. The document covers various topics related to antibiograms including how they are tested, interpreted, and documented. it emphasizes the importance of generating antibiograms using standardized methods and interpreting them carefully based on multiple factors. download as a pptx, pdf or view online for free.

Antibiogram Vector Learn practical examples and tools to leverage antibiogram data and information across your organization analyze and present a cumulative antibiogram at least annually generate local facility specific data include only final, verified test results. The document covers various topics related to antibiograms including how they are tested, interpreted, and documented. it emphasizes the importance of generating antibiograms using standardized methods and interpreting them carefully based on multiple factors. download as a pptx, pdf or view online for free.
Comments are closed.